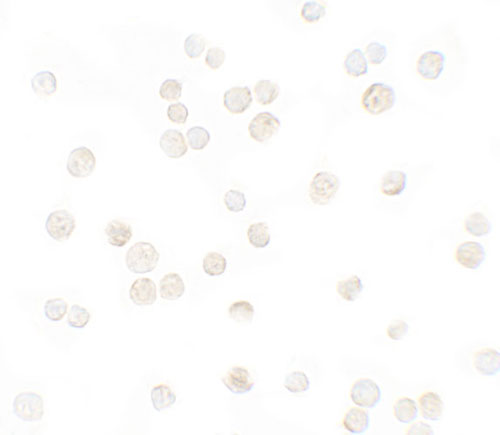

> Antigen, Antibodies, ELISA, Western Blot > Primary Antibody > Polyclonal Antibodies > CXCL12 AntibodyBrand |
Leading Biology | Catalog Number |
APG02924G |
Product Type |
Polyclonal Antibodies | Field of Research |
|
Product Overview |
We constantly strive to ensure we provide our customers with the best antibodies. As a result of this work we offer this antibody in purified format.
We are in the process of updating our datasheets. If you have any questions regarding this update, please feel free to contact our technical support team.
This product is a high quality CXCL12 antibody.
|
||
Molecular Weight |
Predicted: 15 kDa Observed: 18 kDa
|
||
Cellular Localization |
Antigen Cellular Localization:
Secreted.
|
||
Host |
Rabbit
|
||
Species Reactivity |
Human, Mouse
|
||
Target |
CXCL12; CXCL12 antibody is human and mouse reactive. Multiple isoforms of CXCL12 are known to exist.
|
||
Isotype |
IgG
|
||
Symbol |
SDF1, SDF1A, SDF1B
|
||
GeneID |
|||
UniProt ID |
|||
Function |
Chemoattractant active on T-lymphocytes, monocytes, but not neutrophils. Activates the C-X-C chemokine receptor CXCR4 to induce a rapid and transient rise in the level of intracellular calcium ions and chemotaxis. Also binds to atypical chemokine receptor ACKR3, which activates the beta-arrestin pathway and acts as a scavenger receptor for SDF-1. SDF-1-beta(3-72) and SDF-1- alpha(3-67) show a reduced chemotactic activity. Binding to cell surface proteoglycans seems to inhibit formation of SDF-1-alpha(3- 67) and thus to preserve activity on local sites. Acts as a positive regulator of monocyte migration and a negative regulator of monocyte adhesion via the LYN kinase. Stimulates migration of monocytes and T-lymphocytes through its receptors, CXCR4 and ACKR3, and decreases monocyte adherence to surfaces coated with ICAM-1, a ligand for beta-2 integrins. SDF1A/CXCR4 signaling axis inhibits beta-2 integrin LFA-1 mediated adhesion of monocytes to ICAM-1 through LYN kinase. Inhibits CXCR4-mediated infection by T- cell line-adapted HIV-1. Plays a protective role after myocardial infarction. Induces down-regulation and internalization of ACKR3 expressed in various cells. Has several critical functions during embryonic development; required for B-cell lymphopoiesis, myelopoiesis in bone marrow and heart ventricular septum formation.
|
||
Summary |
The CXCL12 protein, also known as SDF1, is a stromal cell-derived alpha chemokine member of the intercrine family. CXCL12 functions as the ligand for the G-protein coupled receptor, chemokine (C-X-C motif) receptor 4 (CXCR4) and CXCR7, and plays a role in many diverse cellular functions, including embryogenesis, immune surveillance, inflammation response, tissue homeostasis, and tumor growth and metastasis (reviewed in 1). Mutations in this gene are associated with resistance to human immunodeficiency virus type 1 infections (2).
|
||
Form |
Liquid |
||
Storage & Stability |
Store at +4°C short term. For long-term storage, aliquot and store at -20°C or below. Stable for 12 months at -20°C. Avoid repeated freeze-thaw cycles.
|
||
Applications |
WB, ICC, E
|
||
Images |

Western blot analysis of CXCL12 in HeLa cell lysate with CXCL12 antibody at 1 μg/ml in (A) the absence and (B) the presence of blocking peptide.
Immunocytochemistry of CXCL12 in HeLa cells with CXCL12 antibody at 5 μg/mL. |
||
Specification |
|||
Quantity |
|
||
| Select | Brand | Catalog No. | Product Name | Pack Size | Type | Field of Research | Specification | Quantity | Price(USD) | |
| 1 | Leading Biology | APR03440G | ITGA11 Antibody (N-term) | 100 μl | Polyclonal Antibodies |
|
$495.00 | Add Ask | ||
| 2 | Leading Biology | APR04537G | CMIP Antibody (C-term) | 100 μl | Polyclonal Antibodies |
|
$495.00 | Add Ask | ||
| 3 | Leading Biology | APR12422G | Human H4 Histamine Receptor (extracellular) Antibody | 50 μl | Polyclonal Antibodies |
|
$695.00 | Add Ask | ||
| 4 | Leading Biology | APR03844G | UBE2W Antibody (C-term) | 100 μl | Polyclonal Antibodies |
|
$495.00 | Add Ask | ||
| 5 | Leading Biology | APR04349G | HECTD2 Antibody (N-term) | 100 μl | Polyclonal Antibodies |
|
$495.00 | Add Ask | ||
| 6 | Leading Biology | APR03502G | IGHG1 Antibody (Center) | 100 μl | Polyclonal Antibodies |
|
$495.00 | Add Ask |
 Leading Biology Inc.
2600 Hilltop DR, Building G, B Suite C138
Richmond, CA, 94806
Tel: 1-661-524(LBI)-0262
Email: info@leadingbiology.com
Leading Biology Inc.
2600 Hilltop DR, Building G, B Suite C138
Richmond, CA, 94806
Tel: 1-661-524(LBI)-0262
Email: info@leadingbiology.com
Complete this form and click send to ask us a question, request a quote or simply say hello.

You have 0 item in your cart

You have 0 item in your inquiry list
